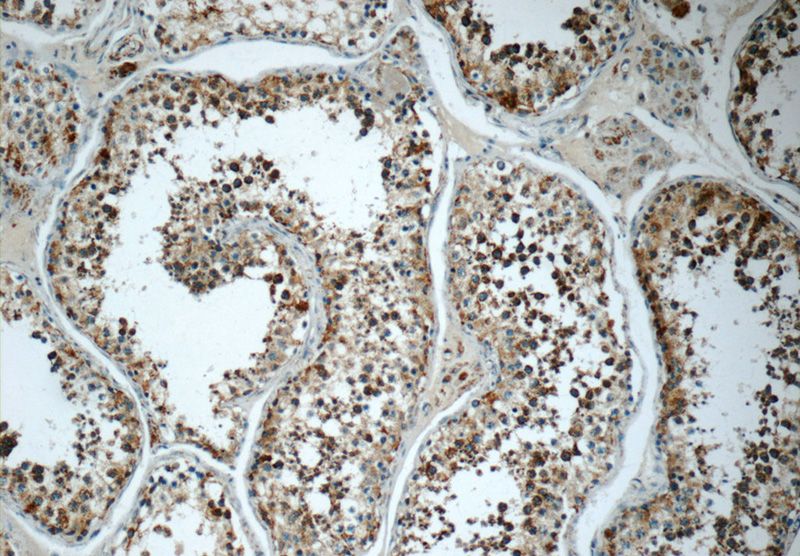
Immunohistochemistry of paraffin-embedded human testis tissue slide using Catalog No:115555(SPATA7 Antibody) at dilution of 1:50 (under 10x lens)

-
Product Name
SPATA7 antibody
- Documents
-
Description
SPATA7 Rabbit Polyclonal antibody. Positive WB detected in mouse testis tissue, PC-3 cells, Y79 cells. Positive IP detected in mouse testis tissue. Positive IHC detected in human testis tissue, human gliomas tissue. Observed molecular weight by Western-blot: 68-80 kDa
-
Tested applications
ELISA, WB, IP, IHC
-
Species reactivity
Human, Mouse; other species not tested.
-
Alternative names
DKFZp686D07199 antibody; HSD 3.1 antibody; HSD3 antibody; SPATA7 antibody; spermatogenesis assOCiated 7 antibody
-
Isotype
Rabbit IgG
-
Preparation
This antibody was obtained by immunization of SPATA7 recombinant protein (Accession Number: BC008656). Purification method: Antigen affinity purified.
-
Clonality
Polyclonal
-
Formulation
PBS with 0.1% sodium azide and 50% glycerol pH 7.3.
-
Storage instructions
Store at -20℃. DO NOT ALIQUOT
-
Applications
Recommended Dilution:
WB: 1:200-1:2000
IP: 1:200-1:1000
IHC: 1:20-1:200
-
Validations

mouse testis tissue were subjected to SDS PAGE followed by western blot with Catalog No:115555(SPATA7 antibody) at dilution of 1:300

IP Result of anti-SPATA7 (IP:Catalog No:115555, 3ug; Detection:Catalog No:115555 1:300) with mouse testis tissue lysate 8000ug.
Immunohistochemistry of paraffin-embedded human testis tissue slide using Catalog No:115555(SPATA7 Antibody) at dilution of 1:50 (under 10x lens)

Immunohistochemistry of paraffin-embedded human testis tissue slide using Catalog No:115555(SPATA7 Antibody) at dilution of 1:50 (under 40x lens)
-
Background
SPATA7, also named as HSD3, may be involved in retinal function. It is interesting to note that mutations in SPATA7 cause LCA and RP/ARRP , two overlapping but distinct human retinal diseases. SPATA7 is another LCA and Juvenile RP Gene.(PMID:19268277) It is a highly conserved, vertebrate-specific protein which expressed in the mature retina. For some modification, the MW always migrate 5-8kd. The antibody can reoginze all the 3 isoforms of SPATA7.
-
References
- Eblimit A, Nguyen TM, Chen Y. Spata7 is a retinal ciliopathy gene critical for correct RPGRIP1 localization and protein trafficking in the retina. Human molecular genetics. 24(6):1584-601. 2015.
- Wang H, den Hollander AI, Moayedi Y. Mutations in SPATA7 cause Leber congenital amaurosis and juvenile retinitis pigmentosa. American journal of human genetics. 84(3):380-7. 2009.
Related Products / Services
Please note: All products are "FOR RESEARCH USE ONLY AND ARE NOT INTENDED FOR DIAGNOSTIC OR THERAPEUTIC USE"
